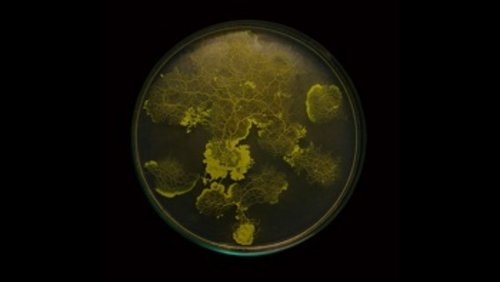

Katja Trinkwalder et Pia-Marie Stute | Exposition Réseaux-Mondes
Playlist
Exposition Réseaux-Mondes
Katja Trinkwalder et Pia-Marie Stute sont deux designers allemandes qui s'intéressent aux effets du numérique sur la vie quotidienne. Avec Accesories for the Paranoid, les deux designers imaginent quatre prototypes qui permettraient de protéger l'espace domestique du système capitaliste de surveillance, où la collecte et le traitement massif des données personnelles semblent abolie le droit à la vie privée.
8
Playlist
Exposition Réseaux-Mondes
Devenu la métaphore du monde numérique, le réseau se donne comme l’un des enjeux majeurs de la société aujourd’hui. Du réseau organique aux réseaux mécaniques, des réseaux immatériels de la société de l’information, jusqu’aux réseaux artificiels et l’emprise d'Internet, l'exposition « Réseaux-mondes » retrace l’évolution de la notion même de réseau.